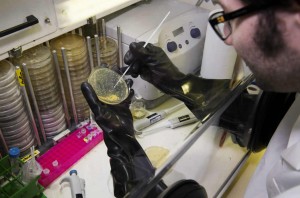
Equipe_recherche_EAD3_photo2

Ingénierie et évolution des voies métaboliques chez les procaryotes
Nom de l’équipe
Ingénierie et évolution des voies métaboliques chez les procaryotes
Sa mission
Analyse exhaustive du métabolisme bactérien. Evolution adaptative sous contraintes métaboliques. Design et création de nouvelles usines cellulaires pour la production biologique de synthons pour la chimie et l’énergie à un rendement maximal.
Mots clés
Métabolisme central bactérien ; Evolution in vivo ; Ingénierie des systèmes biologiques procaryotes ; Bactéries anaérobies strictes ; Hydrogénases, Biocarburants, Molécules biochimiques
Responsable
Isabelle MEYNIAL-SALLES – Maître de conférence INSA de Toulouse
isabelle.meynial-salles@insa-toulouse.fr – 05 61 55 94 17
Effectifs équipe : 11
Permanents : 2 enseignants et chercheurs / 2 ingénieurs de recherche.
Non permanents : 2 assistants ingénieurs et techniciens / 4 post-doctorants et 1 doctorant.
Axes thématiques
- Analyse globale du métabolisme central bactérien natif ou rationnellement modifié
- Etude des relations structure fonction d’enzymes natives ou ingénieurées du métabolisme central
- Evolution adaptative in vivo sous contraintes métaboliques : identification et caractérisation des modifications génétiques responsables du phénomène d’évolution
- Création de nouvelles voies métaboliques et réorientation rationnelle du métabolisme pour le développement de nouvelles usines cellulaires pour la production biologique de molécules d’intérêt pour la chimie ou l’énergie à un rendement maximal
Modèles de recherche
- Analyse du métabolisme central focalisé sur deux bactéries modèles d’intérêt industriel : E. coli et C. acetobutylicum.
- Etude et caractérisation d’enzymes clefs du métabolisme central bactérien : hydrogénase, ferrédoxine, NAD(P)H ferrédoxine oxydo-réductase, thiolase, CoA-transférase.
Domaines d’application et produits cibles
- Domaines : biotechnologies blanches, procédés biologiques pour la production de synthons pour la chimie et l’énergie
- Produits cibles : 1.3 propanediol, butanol, isopropanol, hydrogène, propylène glycol, lactate.
Technologies, techniques, outils spécifiques
- Ingénierie des génomes bactériens
- Ingénierie métabolique
- Ingénierie protéique
- Cultures et modifications rationnelles de microorganismes en conditions d’anaérobiose stricte
- Production, purification et caractérisation biochimique d’enzymes en conditions d’anaérobiose stricte
- Evolution in vivo sous contraintes métaboliques
Publications ou brevets significatifs
- Auriol C, Bestel-Corre G, Claude JB, Soucaille P, Meynial-Salles I. 2011. Stress-induced evolution of Escherichia coli points to original concepts in respiratory cofactor selectivity: Proc. Natl. Acad. Sci. U S A., 108, 1278-83.
- Lautier T, Ezanno P, Baffert C, Fourmond V, Cournac L, Fontecilla-Camps JC, Soucaille P, Bertrand P, Meynial-Salles I, Léger C. 2011. The quest for a functional substrate access tunnel in FeFe hydrogenase: Faraday Discuss. 148:385-407.
- Raynaud C, Lee J, Sarçabal P, Croux C, Meynial-Salles I, Soucaille P. 2011. Molecular Characterization of the glycerol oxidative pathway of Clostridium butyricum VPI 1718: J. Bacteriol, 193, 3127-34.
- Dusséaux S, Croux C, Soucaille P, Meynial-Salles I. 2013. Metabolic engineering of Clostridium acetobutylicum ATCC 824 for the high-yield production of a biofuel composed of an isopropanol/butanol/ethanol mixture. Metab Eng., 18, 1-8.
- Fourmond V, Greco C, Sybirna K, Baffert C, Wang PH, Ezanno P, Montefiori M, Bruschi M, Meynial-Salles I, Soucaille P, Blumberger J, Bottin H, De Gioia L, Léger C. (2014) The oxidative inactivation of FeFe hydrogenase reveals the flexibility of the H-cluster, Nat Chem. 336-342.
Projets précompétitifs
CARBOYEAST (2012-2015) : Capture de CO2 couplée à l’oxydation de l’hydrogène pour la production de molécules d’intérêt industriel dans des levures.